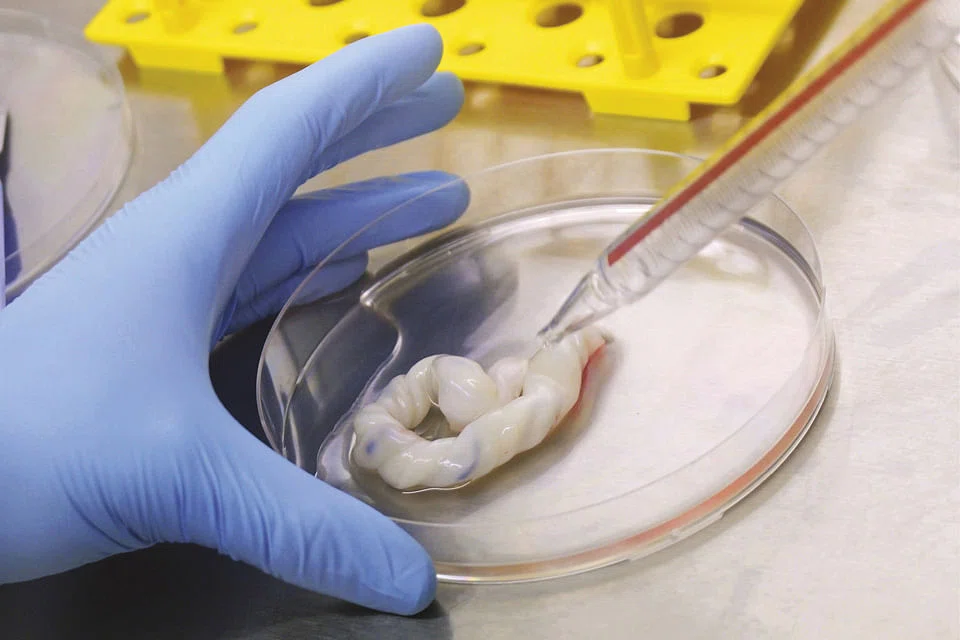

Bonvests, Tai Tak bow out as Cordlife's substantial shareholders
Stake sales will see emergence of Chinese retail giant Nanjing Xinjiekou as major shareholder

Anita Gabriel
Singapore
THE "play" by Cordlife Group's two longtime substantial shareholders - less than three months after they demanded board seats in the cord-blood banking firm (they got their way shortly after) - has taken an unexpected yet possibly promising turn.
Singapore-listed Bonvests Holdings and Tai Tak Estates Sdn Bhd are selling their 20 per cent interest (each is selling 10 per cent) in Cordlife to China's retail giant Nanjing Xinjiekou Department Store for S$86.6 million or S$1.67 a share - a sweet 32 per cent premium over Cordlife's S$1.265 closing price on Thursday, a day before the announcement on Friday.
TRENDING NOW

Buyer for England striker Harry Kane’s former mansion must pay £3.4 million after abandoning deal

Malaysian tycoon Vincent Tan’s sell-downs point to pruning rather than an exit plan

OUE Reit selling Crowne Plaza Changi Airport for S$500 million; unitholders to get special payout

Asean must retain more value as its digital economy races towards US$2 trillion: Indonesian minister